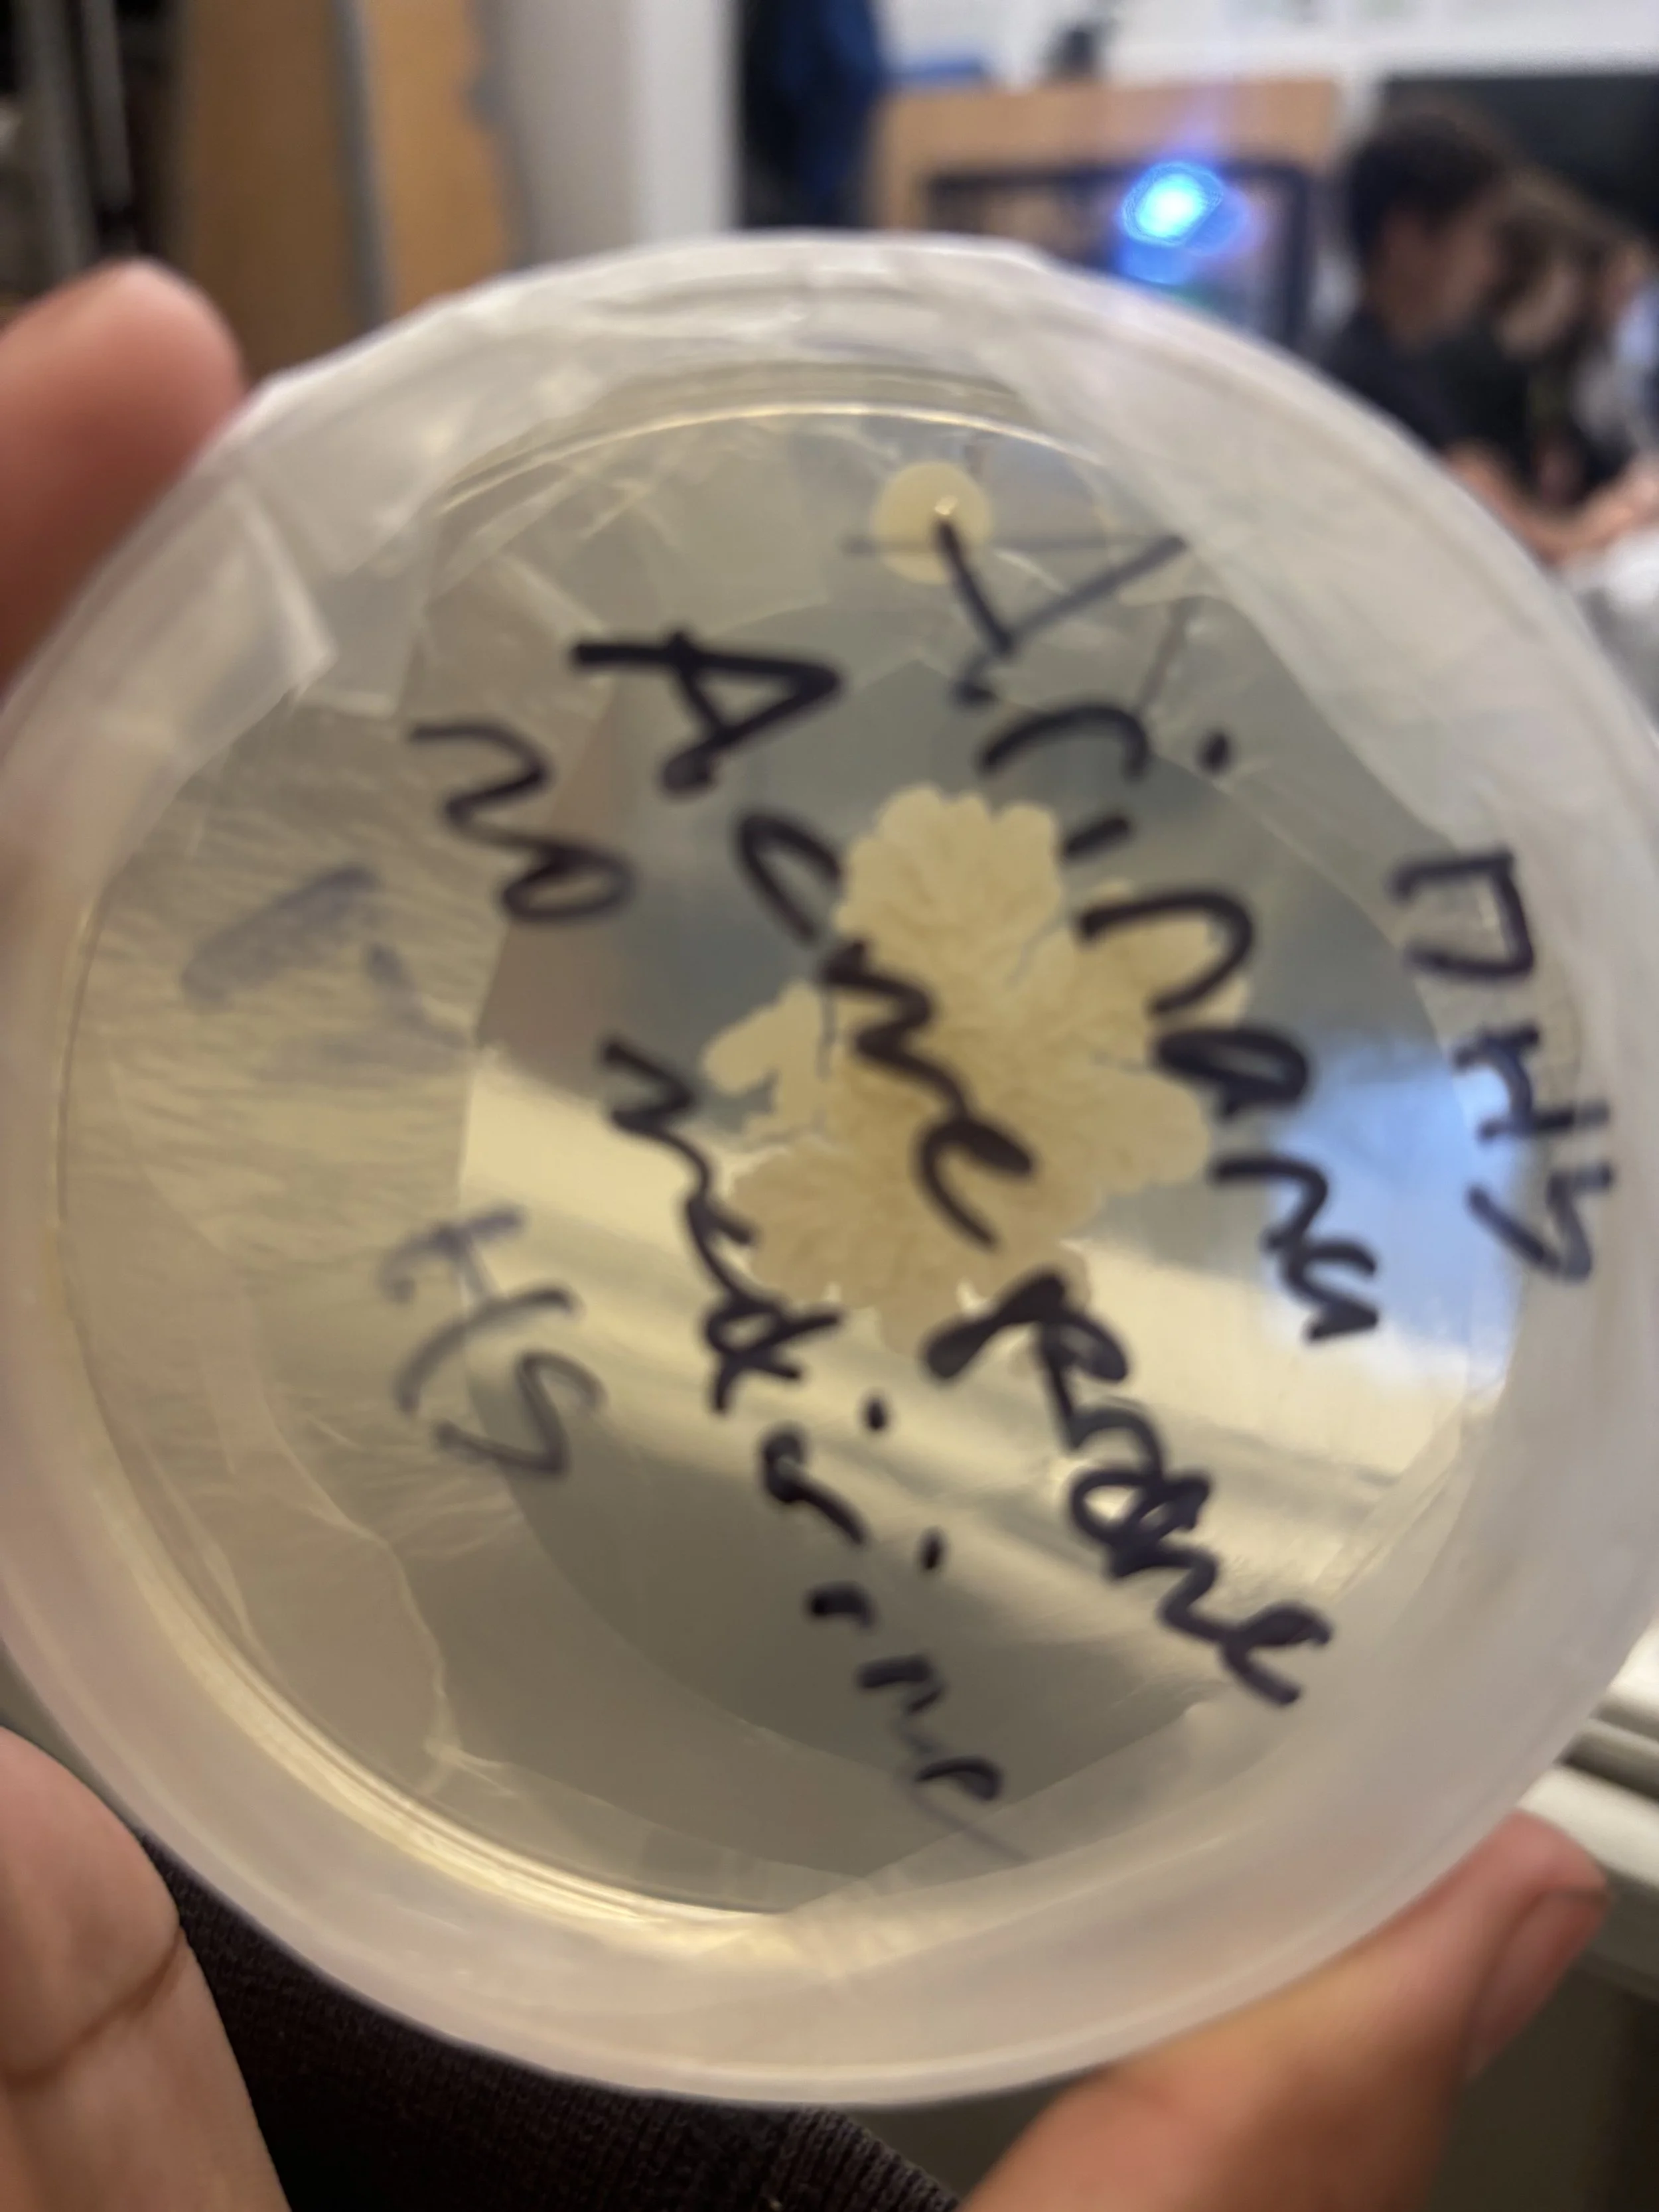
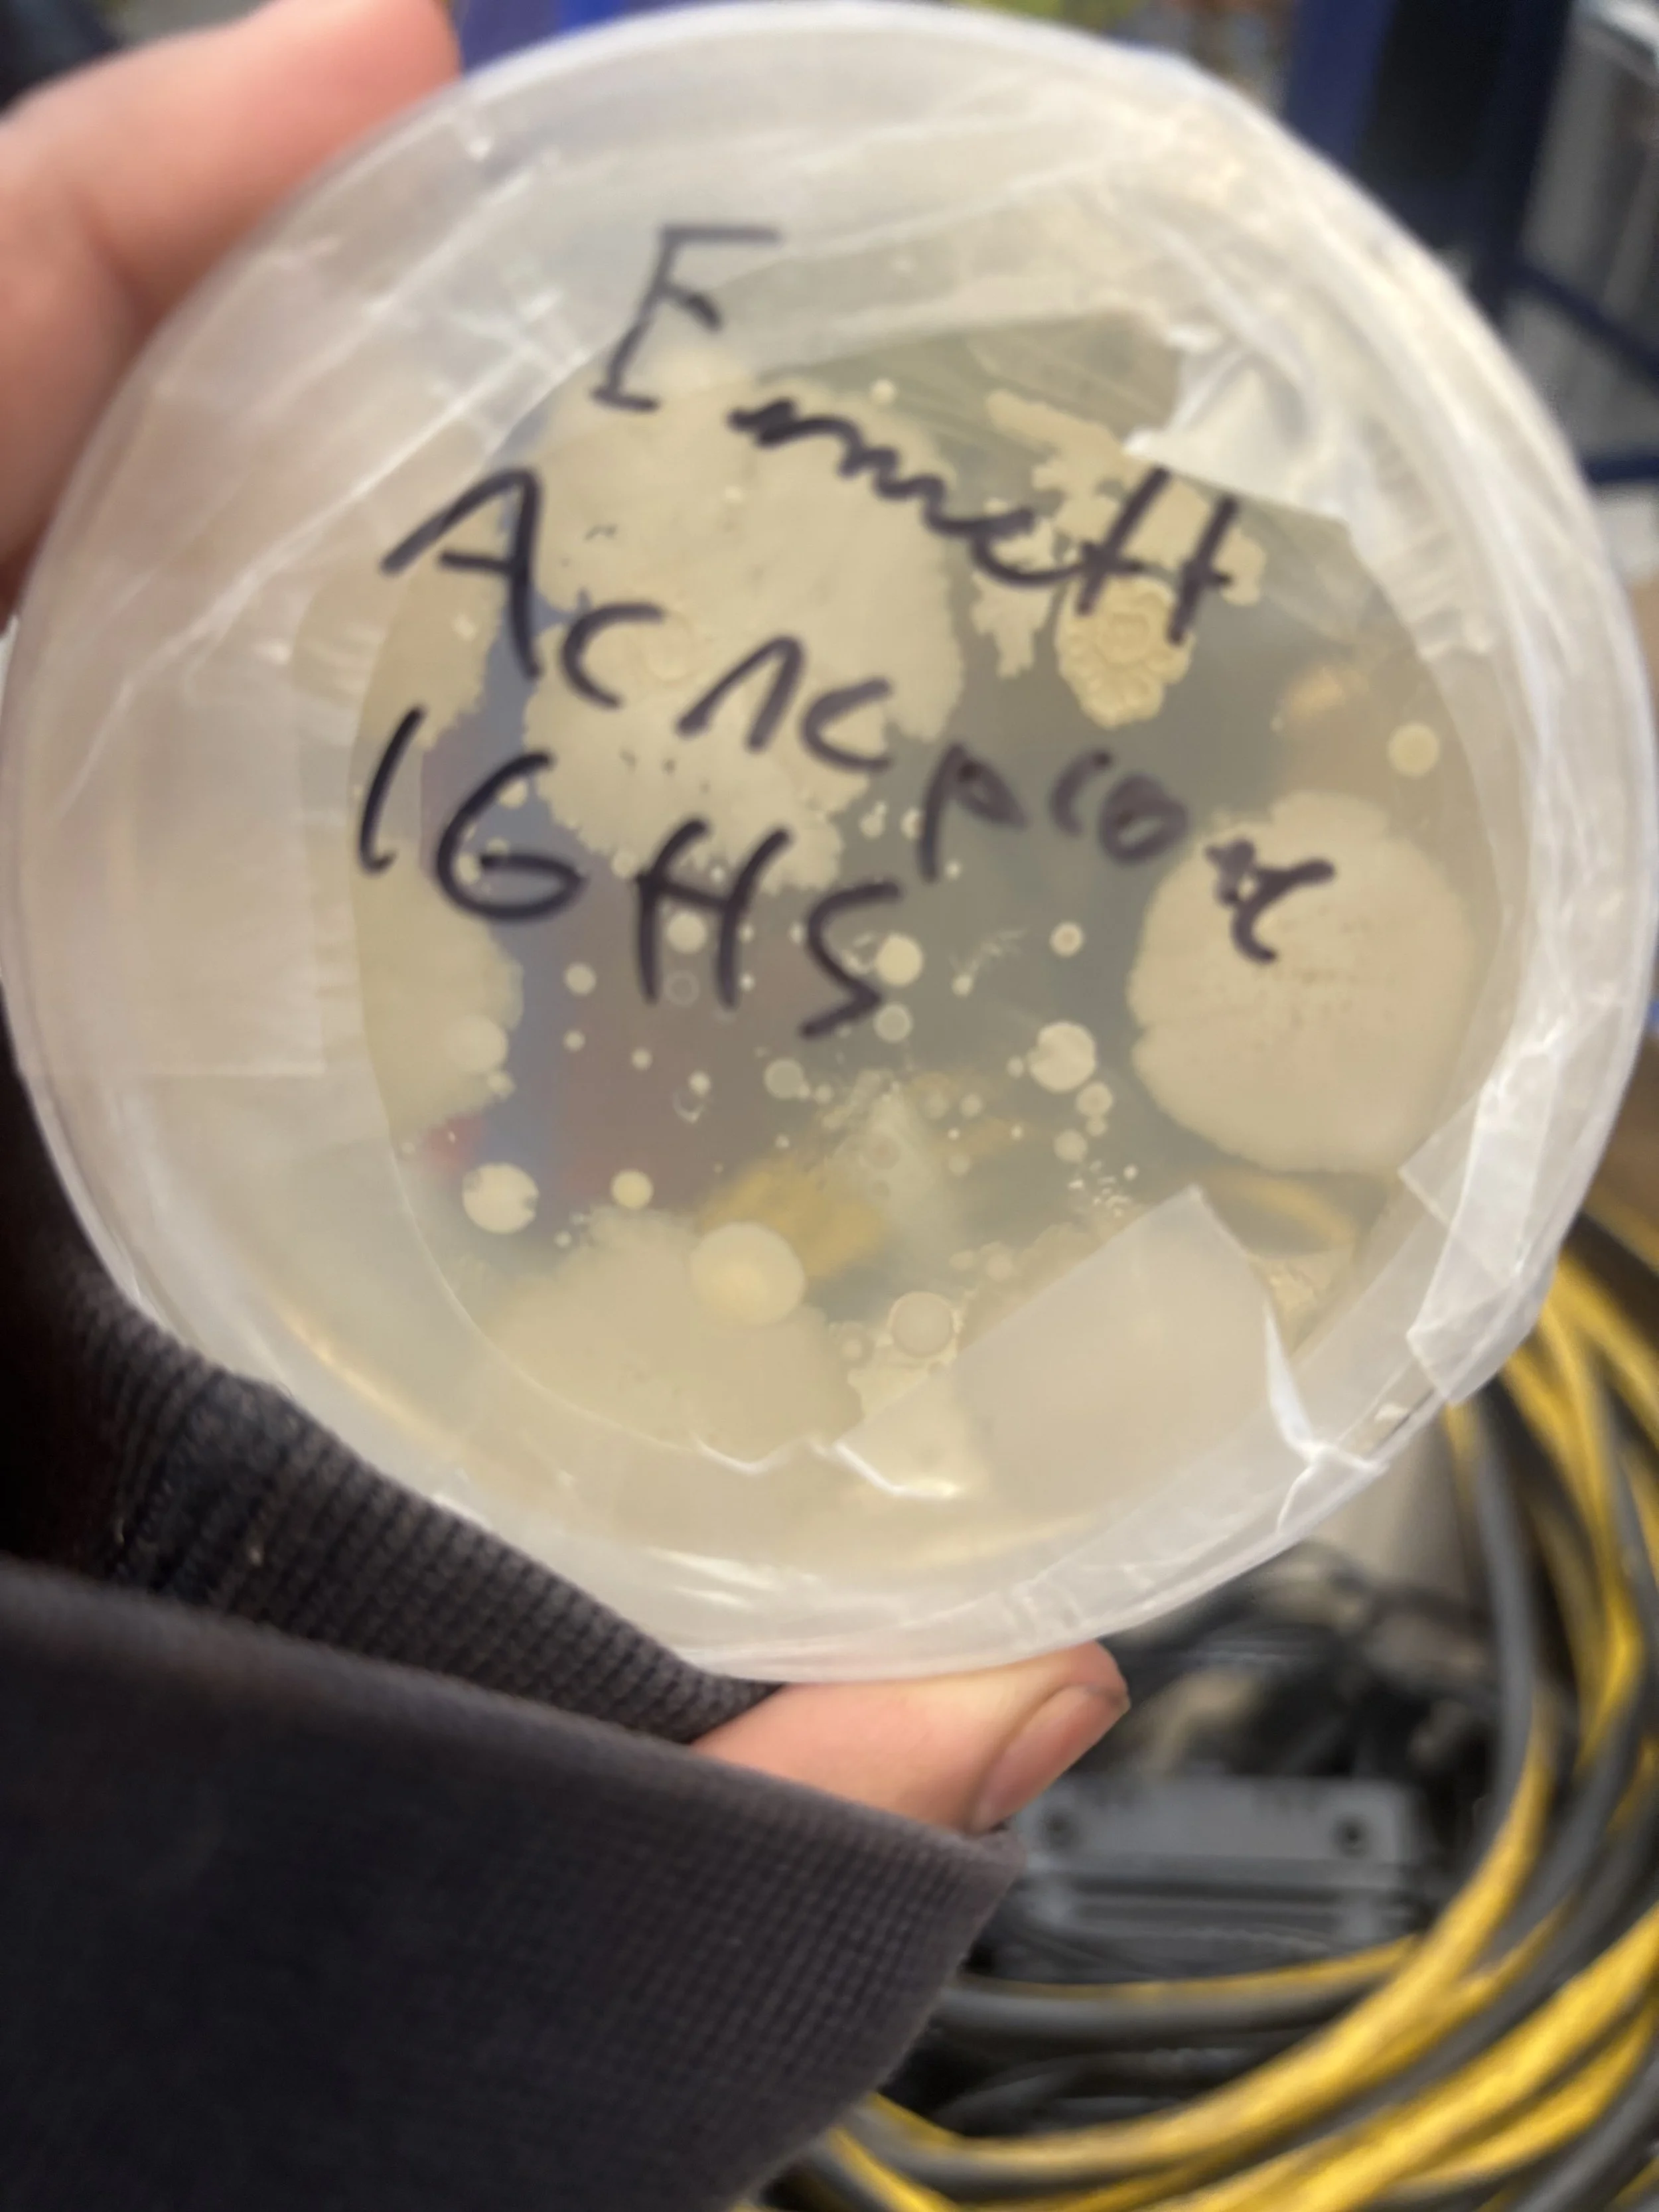
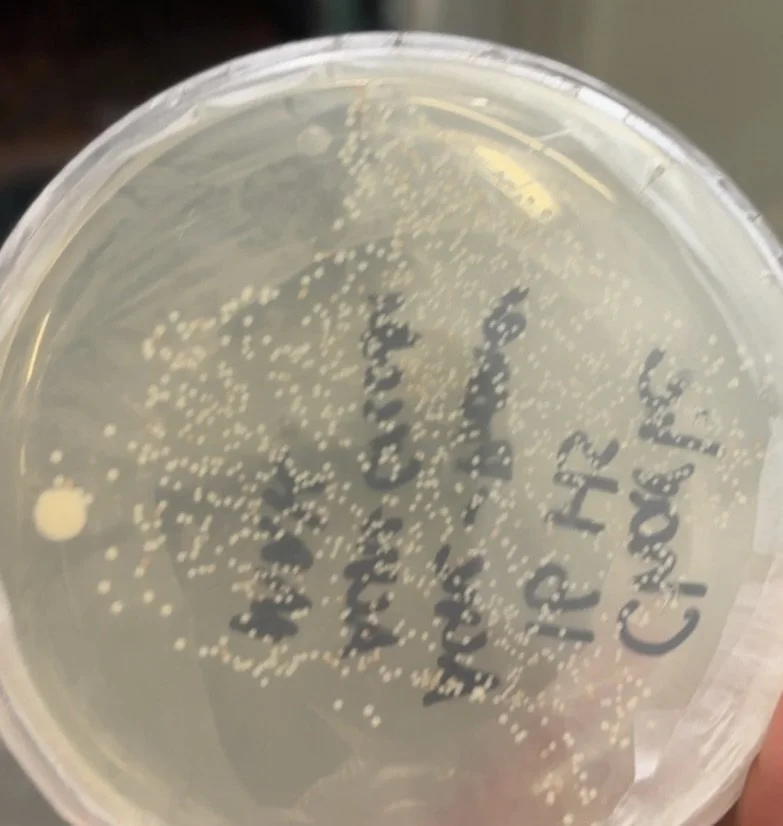
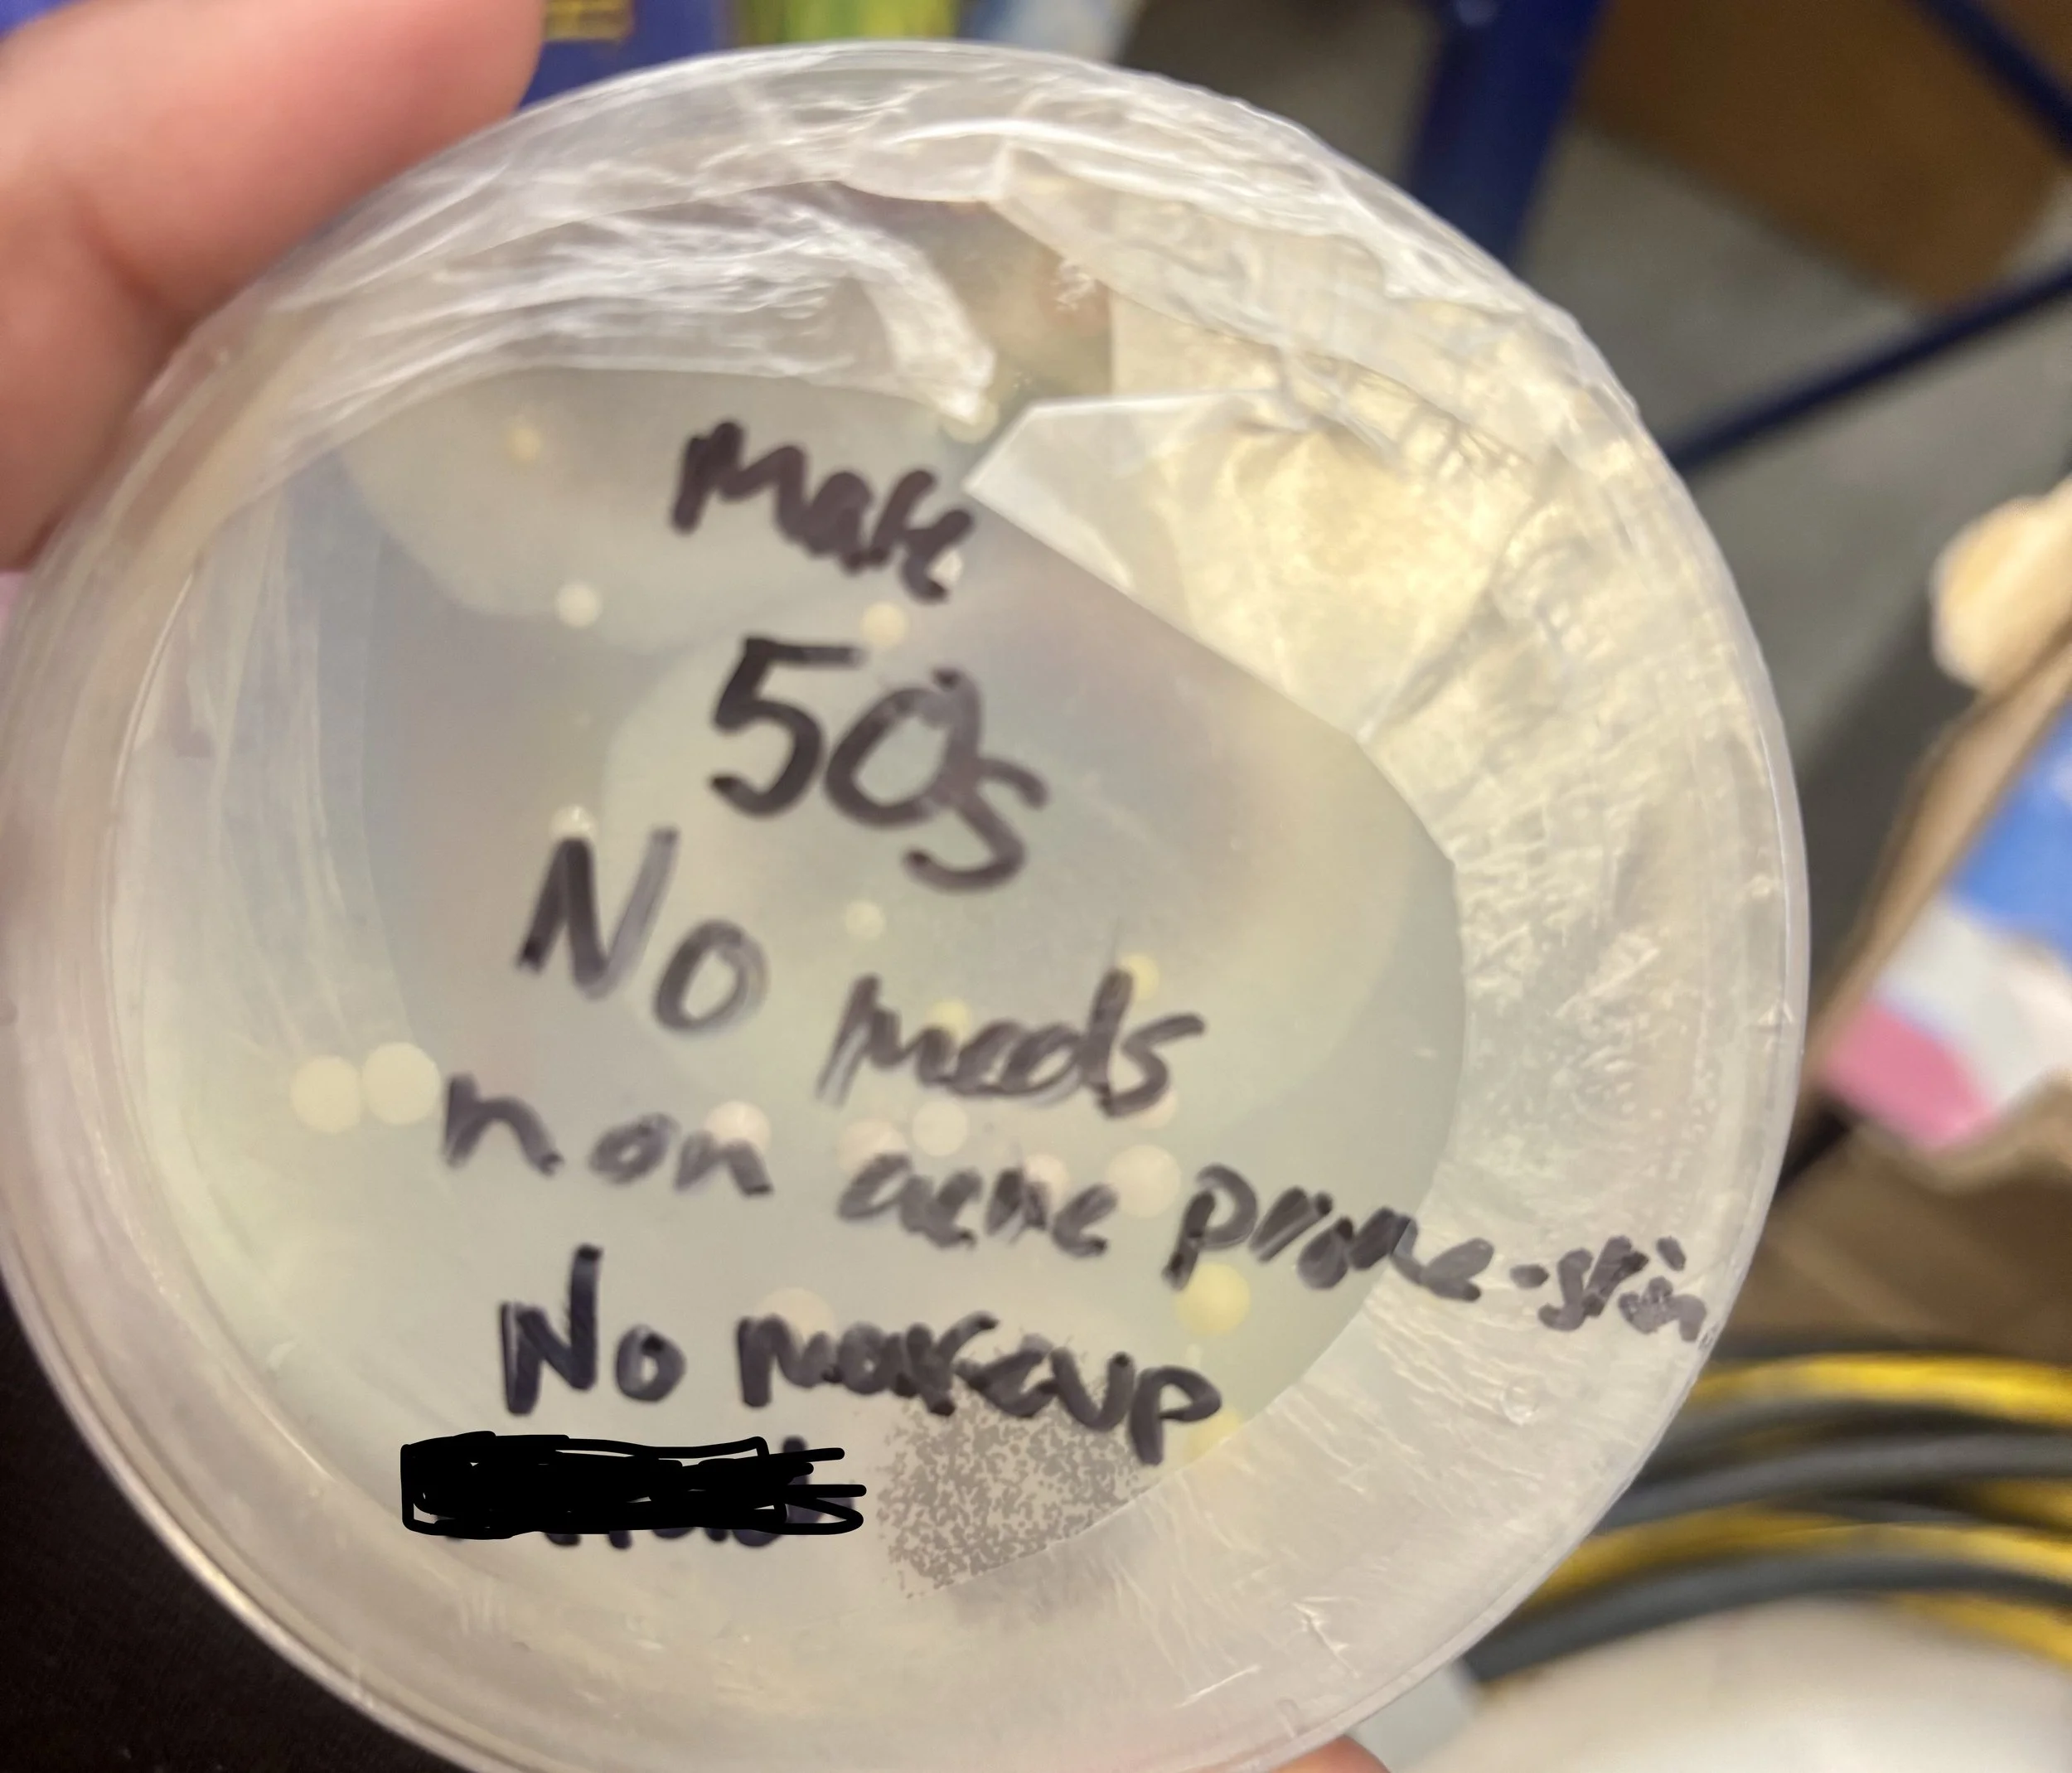
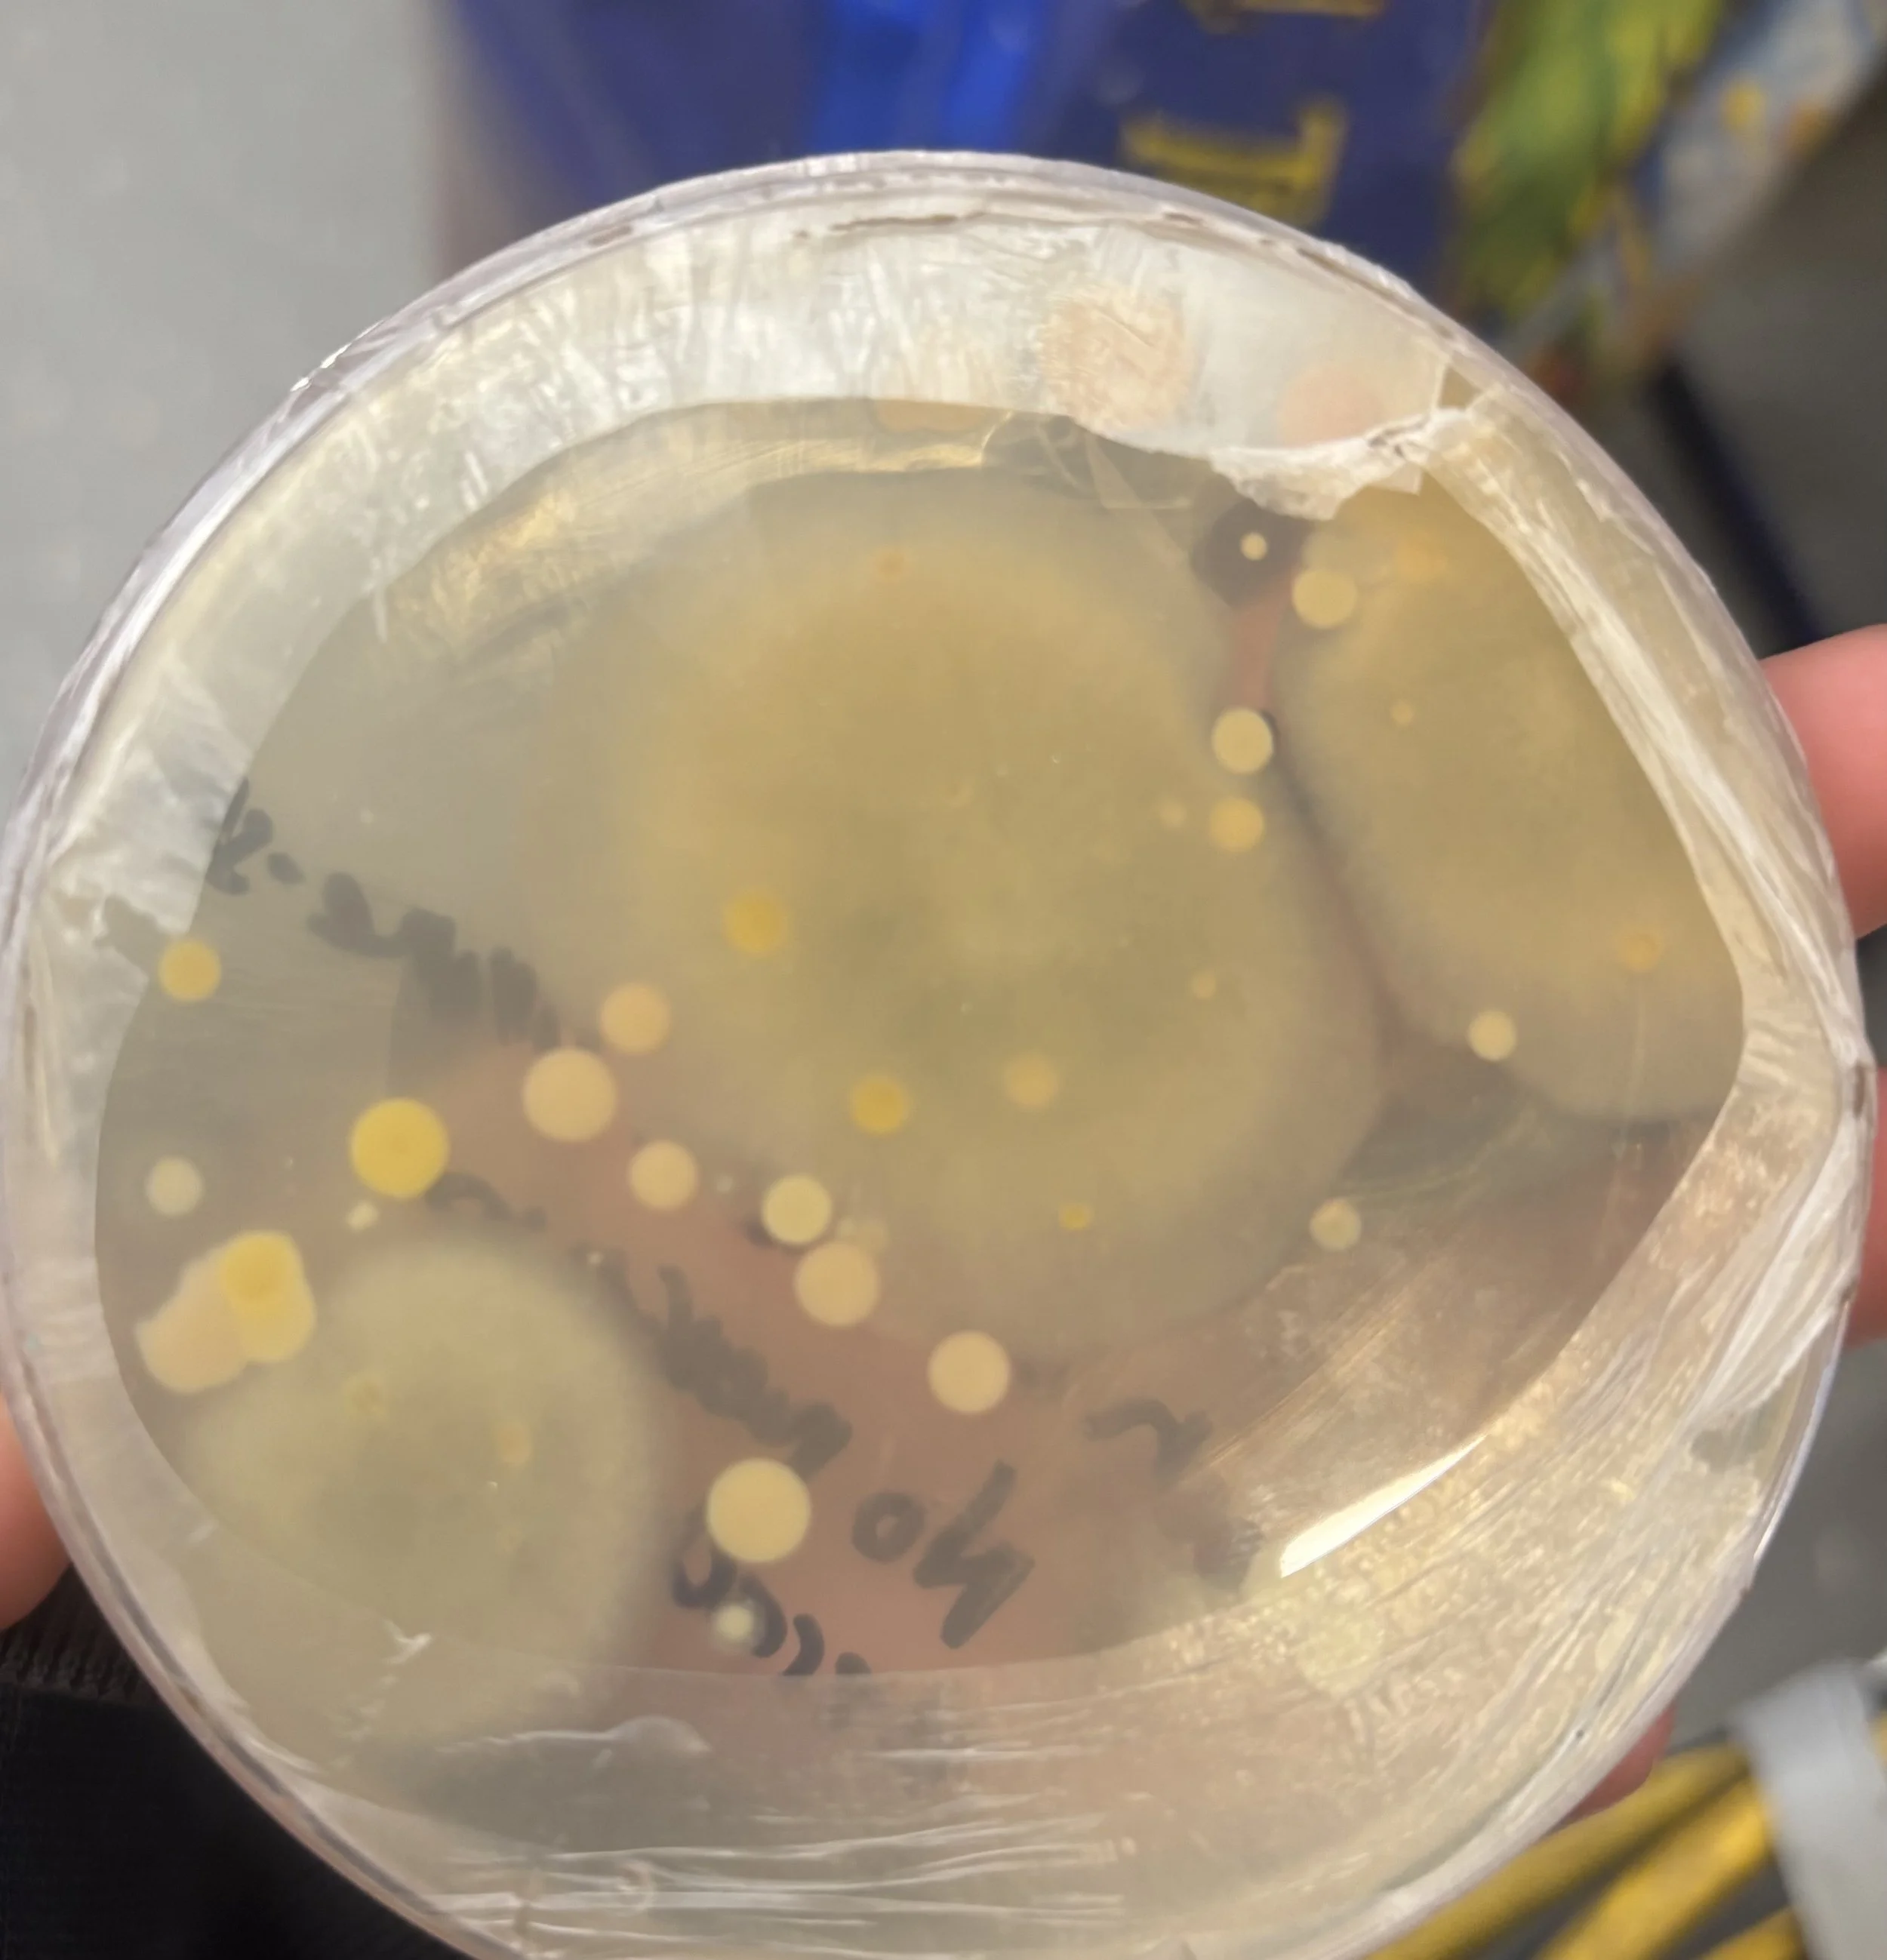
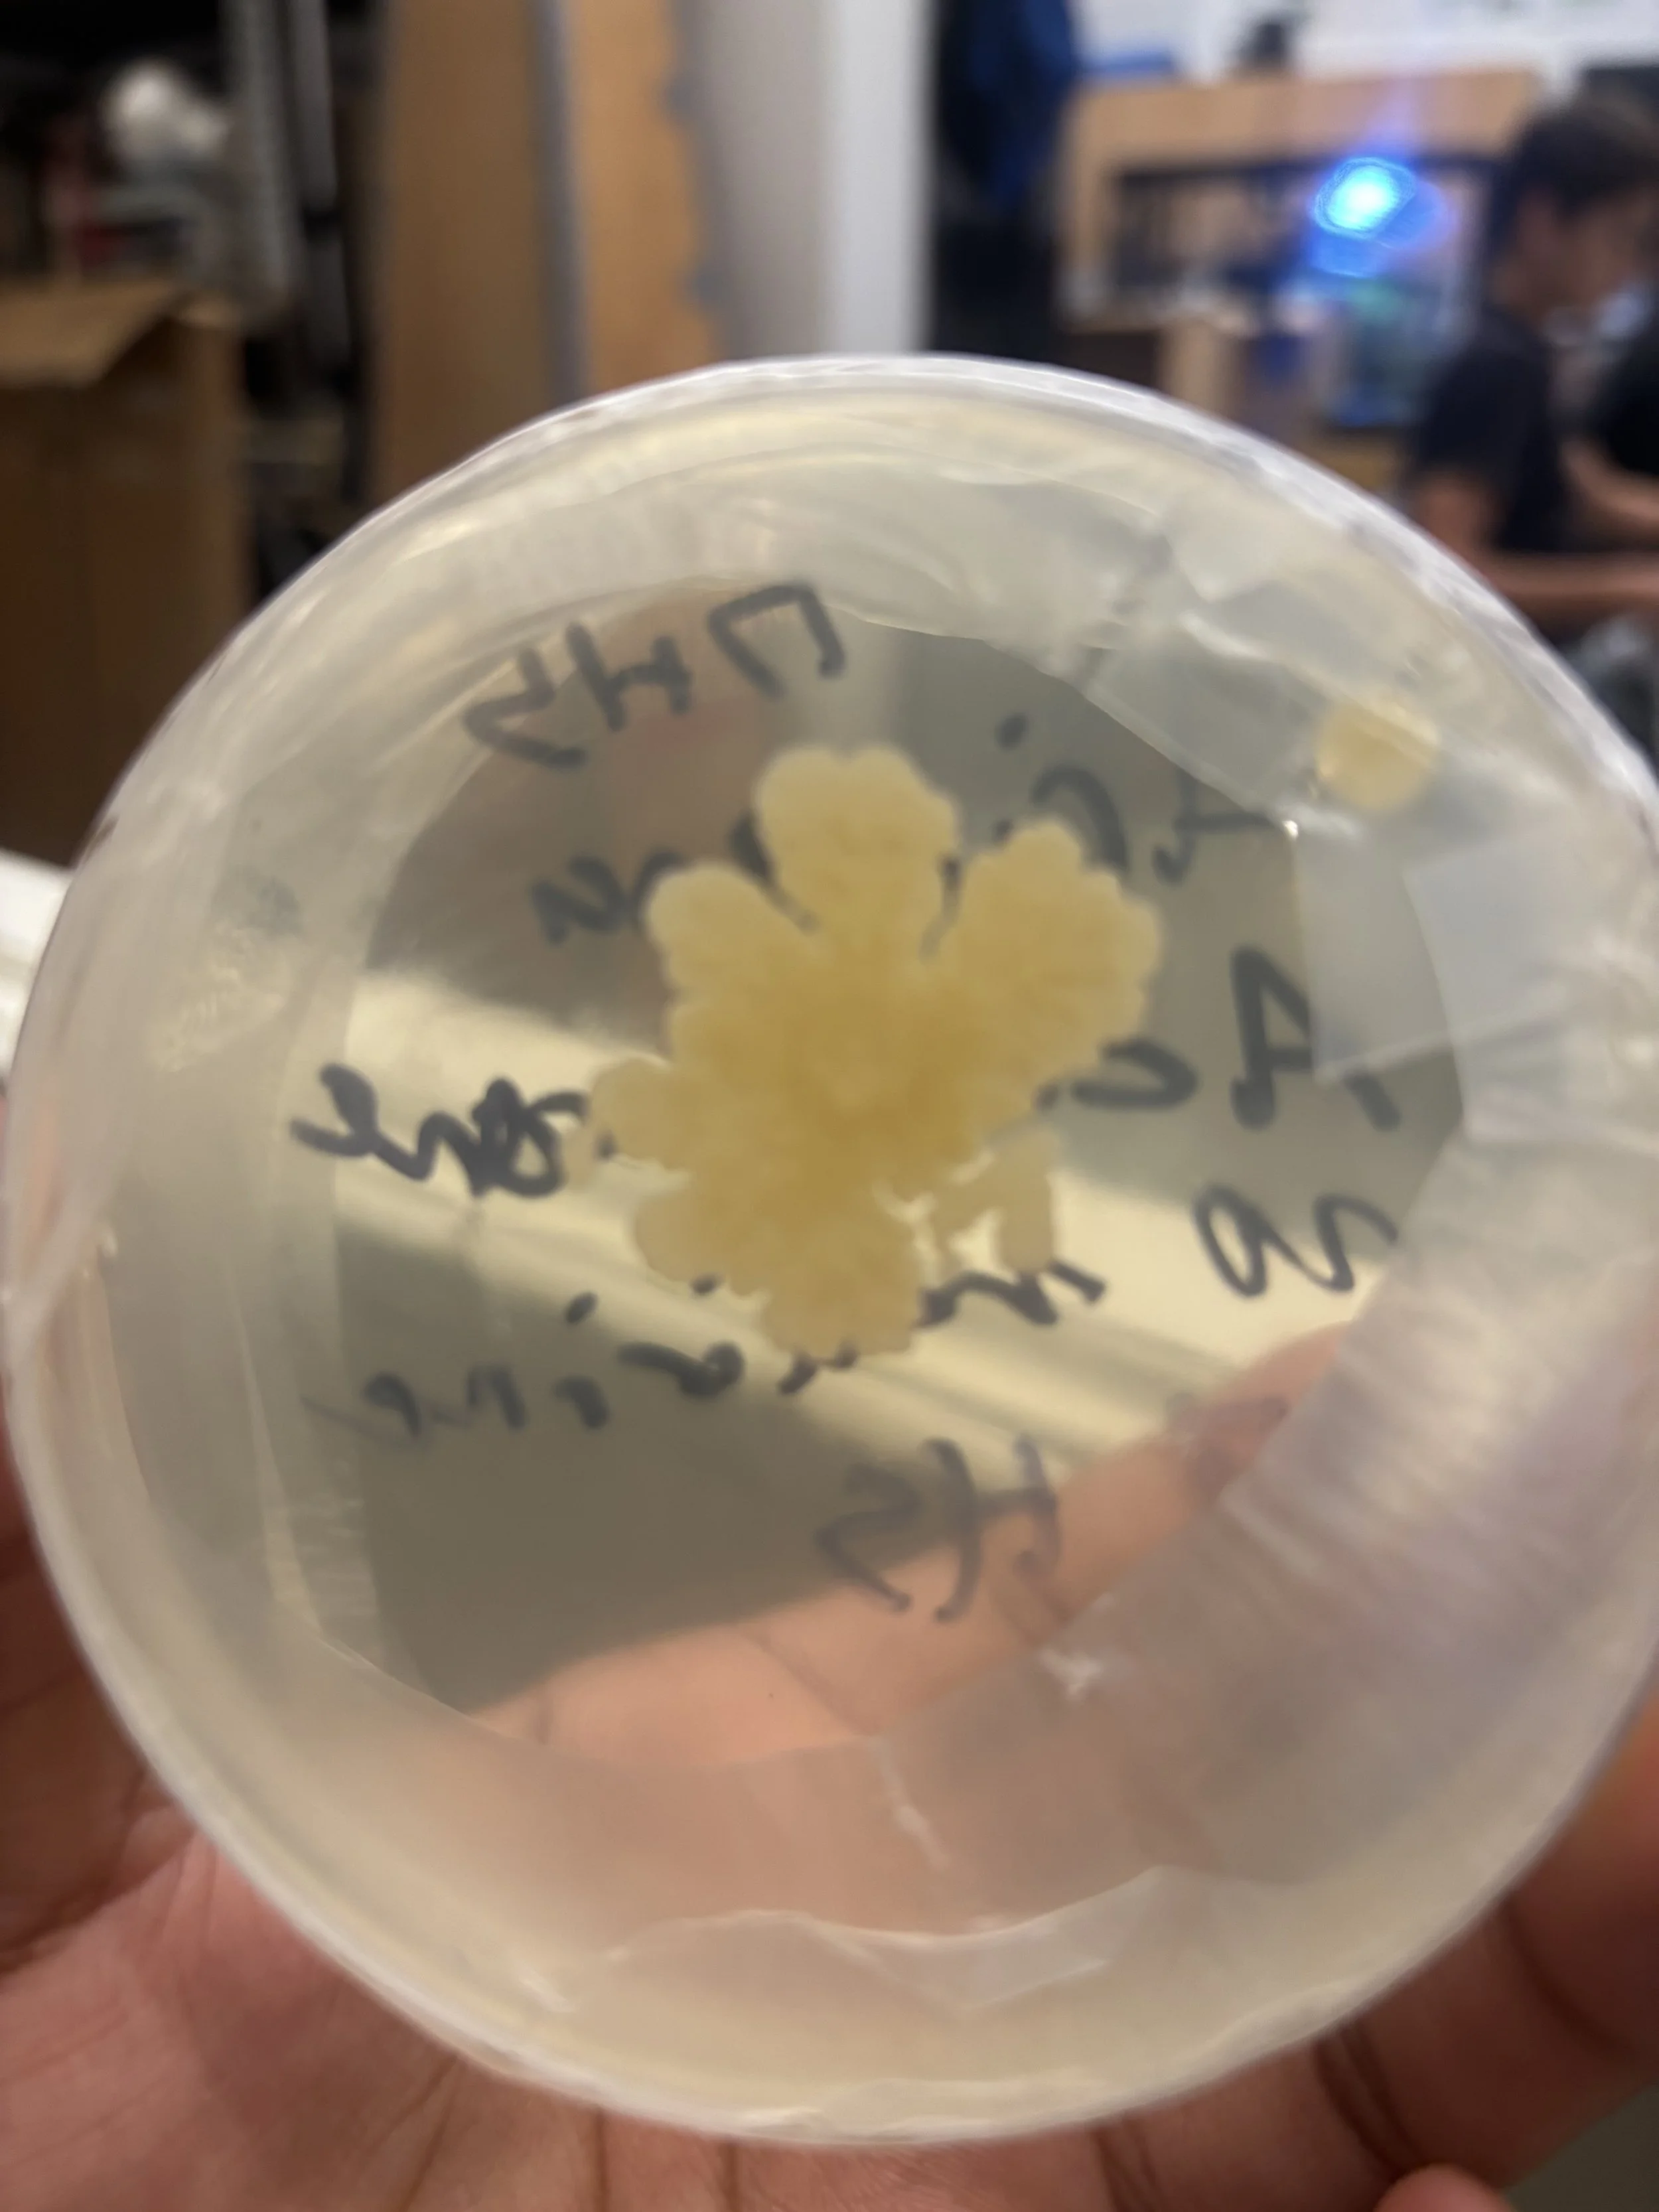
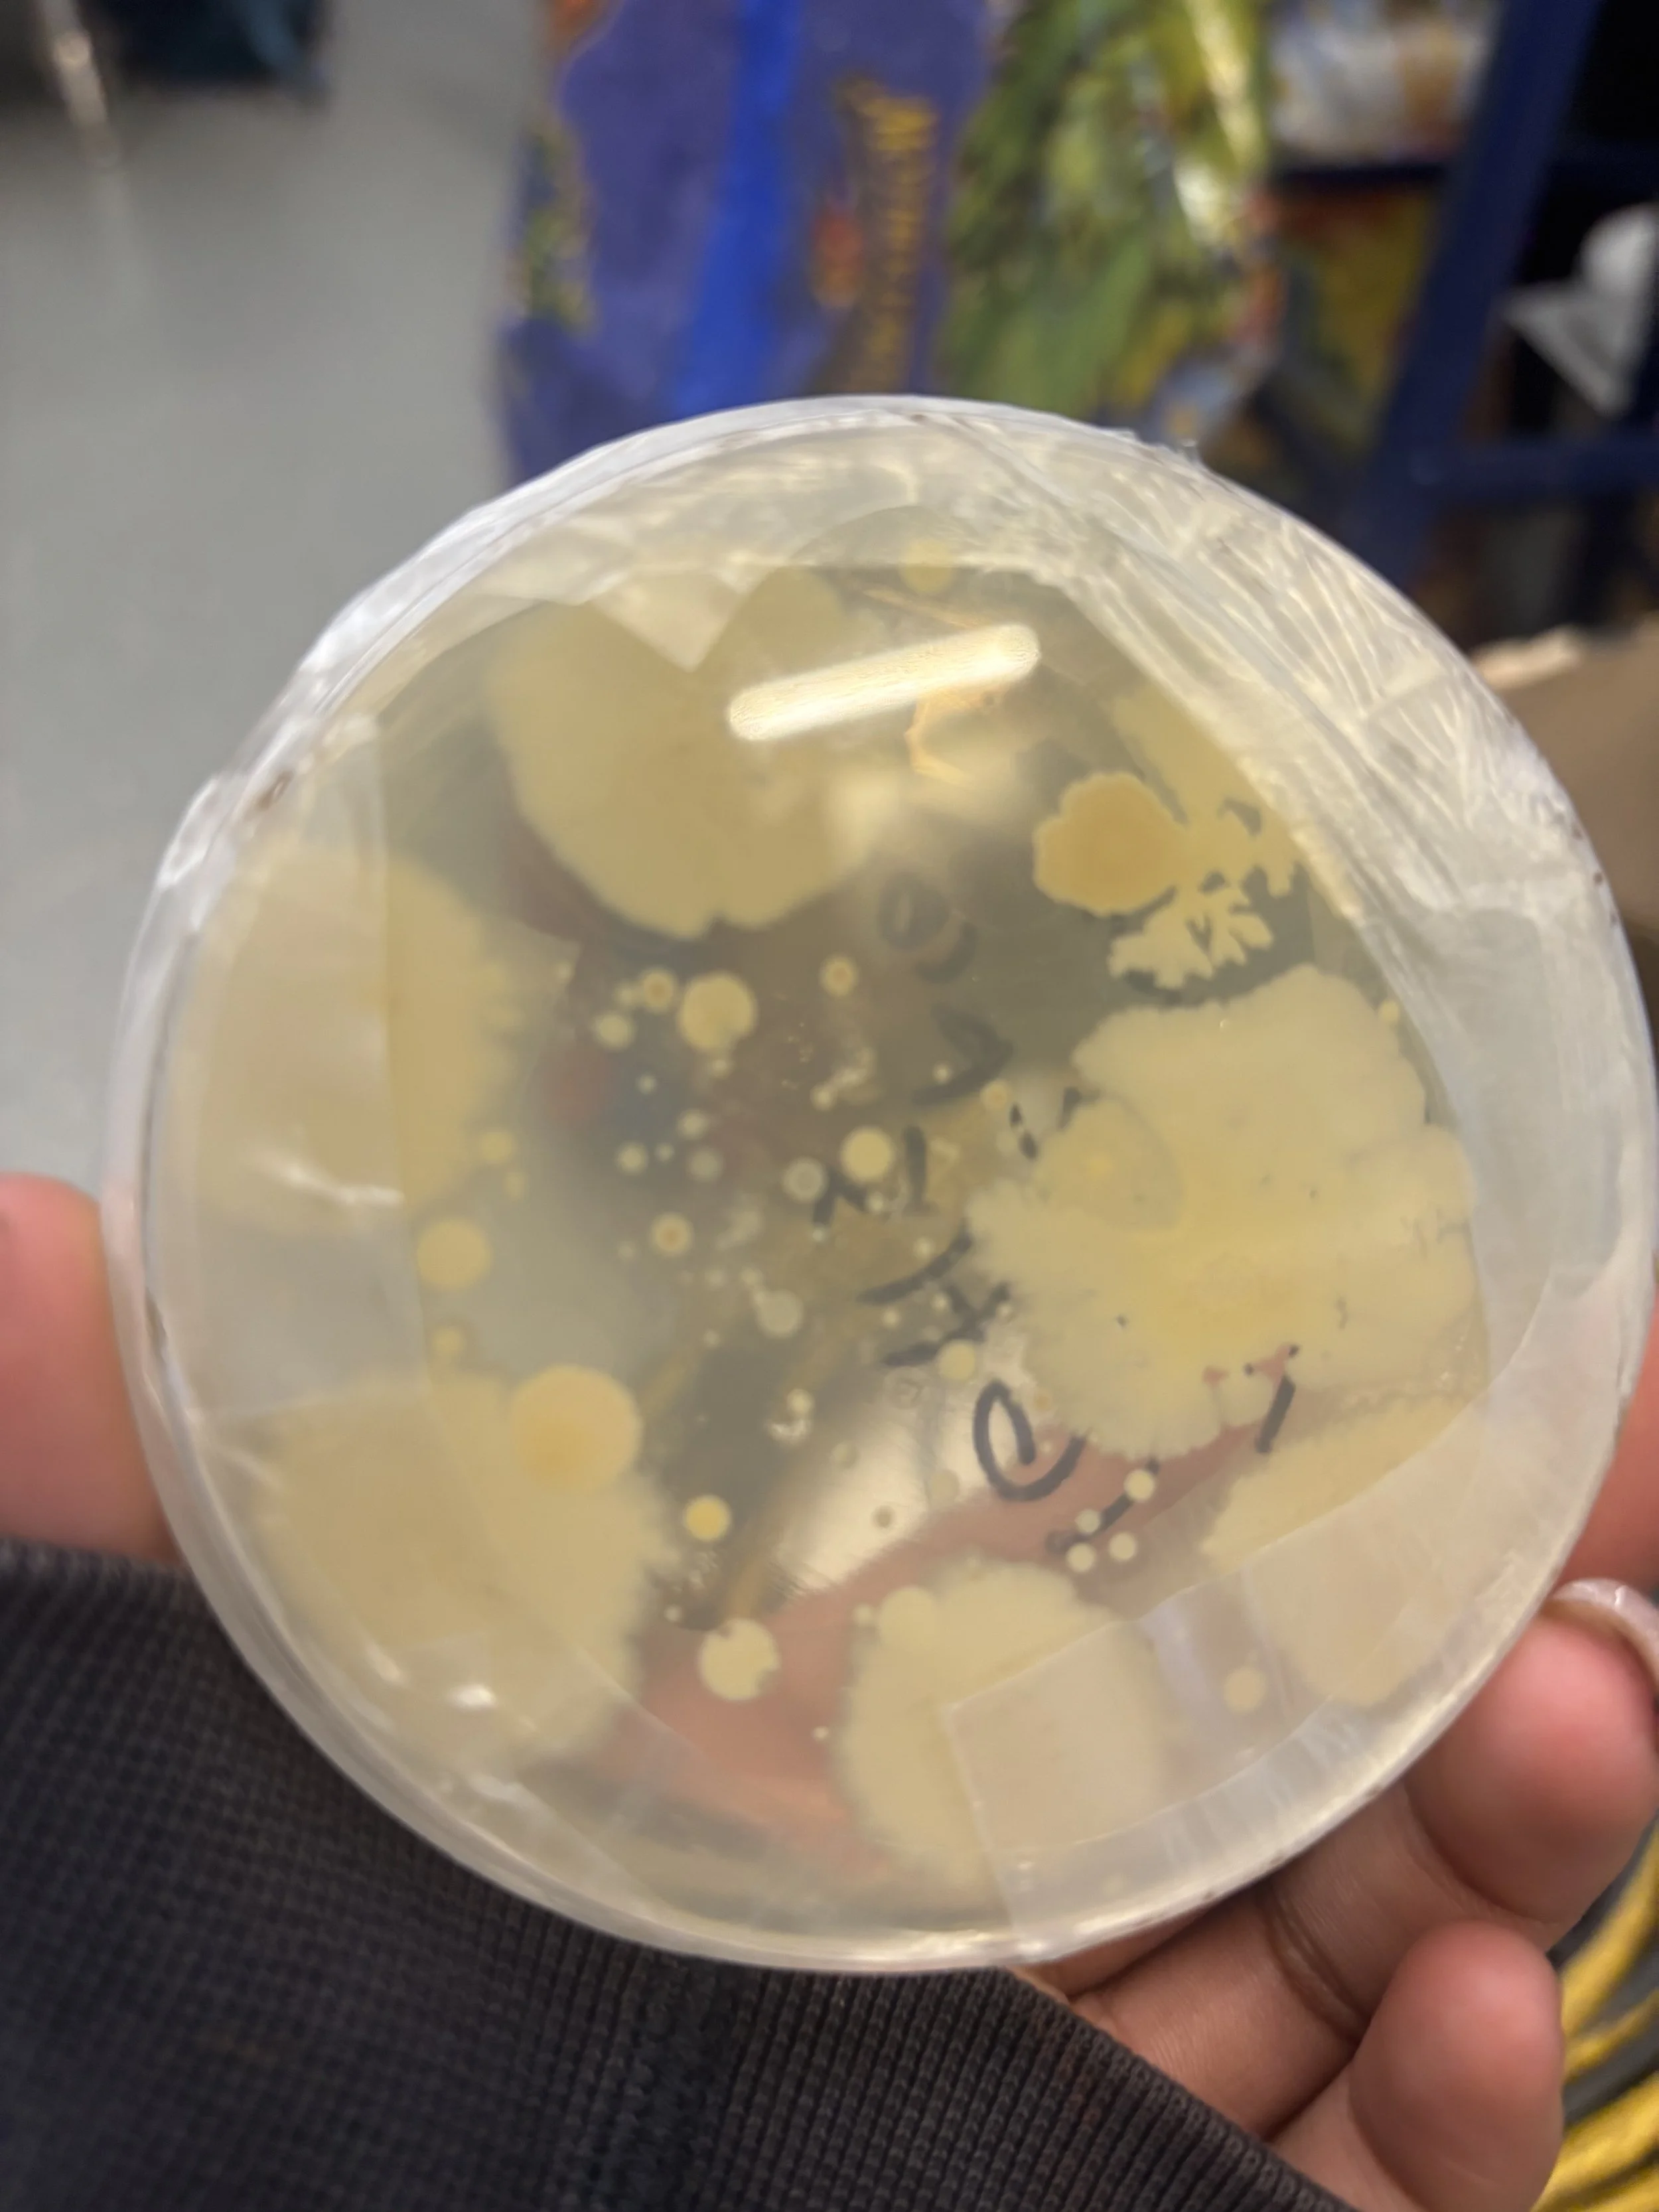

Justice S.
WISRD Member

Journal 2024-2025
Introduction
This is my first year participating in WISRD. I hope to be able to create a product that will be useful and effective for people who have struggled with their skin. I would love to get support and more insight on something I would like to focus on in the future. I first started by focusing on researching about my product, and then once I had a plan laid out, I began to create the product. In WISRD, I would like to first create a makeup foundation that will improve face acne. I would like to research and find ways to create a makeup product like foundation that can also be an acne treatment. Then, once my product is created, if given the chance, I would like to take WIE in my senior year to learn how to start and run my own business for my upcoming company. My future goal is to start my own brand of makeup products that benefit the skin.

This is a part of my research to get a basic understanding of facial skin
Research

This is my research on acne, finding what exactly it is and the cause, and how I can treat this problem

This is my research to find foundation ingredients that will be able to treat acne in the process of being a beauty product
This was from a face swabbing test to see how much bacteria was collected from different skin types


This is an example of a Hispanic female and male sample that we collected. As compared to other samples from Hispanic students, their skin tends to be more oily.
This research led me to my decision to make a water-based foundation rather than an oil-based one. For people with naturally oily skin, an oil-based foundation adding more oil to the skin will clog pores and increase acne


This is a sample of African American female and male skin. Similar to what I noticed in Hispanic skin types, African Americans tend to have more oily skin.

Iron Oxide to add pigment to foundation
Ingredients


Xanthan Gum to thicken the foundation

Glycerin to help moisturize deeper layers in the skin

Phytic Acid reduces the appearance of pores
Adapalene helps treat acne

Benzoyl Peroxide unclogs pores

Panthenol helps moisturize the skin and soothe irritations and acne


Hyaluronic Acid hydrates the face without clogging pores and duce inflammation and associated with acne

Salicylic Acid prevents and clears acne by reducing redness and unclogging pores

Argan Oil can help treat acne by regulating the oil on your skin

Arrowroot powder replaces talc provides relief to skin irritations and helps acne

Emollient cream for dry skin smooths the foundation, which hydrates and softens the skin and helps the application process
Aloe vera helps hydrate the foundation and skin in order for a smooth base

Liquid Hyaluronic Acid hydrates foundations and thickens foundations
The Process of mixing and breaking down the Iron Oxides to get a pigment color to my liking

Production



The process of heating water and adding the iron oxide pigment into the heated water

The next step I took was adding glycerin, arrowroot powder, and xanthan gum into the heated water with pigments

After adding the rest of the ingredients, I split half of my product into a testing tube, placing one test tube in the fridge, and the other half stayed in a test tube that would be placed out in the classroom to be room tempter to see how the different tempters affect how the product settles.

These are different trails in making my product, none being my ideal liking, so I have recently requested extra ingredients to fix the texture to my perfect texture for my foundation

An image of me adding iron oxide to the hot water




I have recently tried to create a product with a better texture. In doing that I changed up some measurements and ingredients. I first added less water making a smaller amount then adding a lesser amount of the main ingredients I normally would add into the water. Those ingredients (in order) are Liquid Hyaluronic Acid, Glycerin, Arrowroot Powder, Benzoyl Peroxide, Panthenol, Iron Oxide, Argan Oil and Emollient Cream.

This is the current tester I am working with, it is not super thick like the other ones but it is too watery now. I need to figure out how to make the product into a more creamy texture and have coverage on the skin to cover any blemishes on the face.


Yesterday February 5, I added more iron oxide to have more pigment in the product for coverage. I also added more Glycerin in the hope of a more thicker texture. The product’s texture result by the end of class had double the amount of pigment than before and was a little less watery. My ideal texture for this product is to have a cream texture type, so with hopes of that today I will be adding in more arrowroot powder and maybe Xanthan gum to thicken out the product’s texture.
Image of the product after adding two more spoon fulls of Iron Oxide (pigment)
Image of the product after adding Arrowroot Powder, Glycerin, and Hyaluronic Acid


The product that only Glycerin was added to


The Product Glycerin, Iron Oxide, and Arrowroot Powder was added to.
Yesterday February 10, I decided to separate the product into only adding glycerin in one half of the product and the other product adding not only glycerin but also more iron oxide for more coverage and arrowroot powder to thicken it. The finishing product had a way better texture, similar to the foundations I use from current makeup brands. The foundation needs to have more coverage and a good texture once it has dried while sitting on the skin. Today, I will add more iron oxide, some emollient cream, and argan oil for a creamy finish to the product.
Feedback: Its texture was the best out of all the products—although the after effect had some strength and stretches. Once the product was rinsed off, the skin felt very hydrated and smooth. While the product was on, it wouldn’t blend into the skin fully, and once it dried, the pigment would sort of fade. I have tried many different ways with the ingredients I have from my research, and my product is still not coming out how I would like. I feel I need more background research from a professional, like maybe getting in contact with a cosmetic chemist to at least get a good understanding of how regular makeup is made.
As I highlighted in my feedback that is my main goal currently, to possibly get into contact with a cosmetic chemist to get a better understanding on how makeup is made. With a better understanding on how makeup is made I will be able research specific things and their replacements to create an acne prone foundation
Internships
Friday, May 9th, I have an interview with Kaiser to get an internship there during the summer. In hopes of getting an internship at Kaiser, I will be able to work with Dermatologist. This is not only beneficial in getting more educated about the skin, but it will also help my process in making a product.
future makeup product ideas:
overnight makeup products
-long lasting
- works as an overnight sleep mask
This year, my goal is to develop a complete foundation product that will benefit those with acne. I am about to start my face swabbing research once again, this time aiming to gain a deeper understanding of the bacteria collected.
Who to Swab:
Group by skin condition
- Group A with acne prone skin (severe and mild acne)
- Group B with non acne prone skin (clear skin)
Group by Gender
- male, female, nonbinary, or transgender
- hormonal difference
- hormone treatments
9/26 Day 1 Swab Samples

9/30/25 Day 4 Swab Samples

2025-2026
10/3/25 Day 5 Samples
Research Questions for Face Swabbing Research:
What bacteria are commonly grown on the facial skin?
What types of bacteria are shown?
What types of bacteria are primarily shown on acne-prone facial skin compared to clear skin?
What beneficial/protective bacteria are present in non acne prone skin that are missing in acne prone skin?
What to collect while Swabbing:
Age
-Acne type shifts with age and hormones
Use of acne medication
Skincare Routines/ Use of Makeup
What type of products are used daily
Natural or Chemical based products
9/25 - I will begin face swabbing tomorrow, collecting samples from individuals with both acne prone and non acne prone skin. When swabbing people, I will collect the information on their age, the use of acne medication, the use of products used daily, and the use of makeup

10/3/25 Day 5 Samples
Notes:
16 year old male, acne-prone skin, no makeup use, no acne medication use
I noticed lots of little white dots scattered in this sample
Future Note & Questions
I noticed a mini white circular figure, maybe a fungus?
Will the white fungus grow? What type of fungus is it?
Notes:

Meeting with Product Devloper
I was able to get in contact with the product developer from the makeup company Haus Lab. I gained more clarity on the makeup industry and received guidance to develop my project further.
Highlight Notes From Meeting
Not a lot of research is out to the public on developing, making products, and the ingredients.
Most makeup companies don’t have an in-house lab, so they use different labs/vendors to create different products
A factor in choosing which lab is for what products you're making (dry and wet labs)
Most foundations seen in stores have about 20-40+ ingredients
If decided to intern at a makeup company, she suggested the makeup company NXY
If decided to intern at a vendor, she suggested Collar Pop Factory
They do everything in house - chemist in the lab creating products, product developers testing out products, marketing team, and shipping out products
She suggested I work on my base first, perfecting that, then further my process to finish to foundation
Next Steps
Im going to look more into Collar Pop Factory to see if I can get an internship opportunity with them
If not possible at Collar Factory, then I will find a lab to potentially intern under a cosmetic chemist
I am also getting in contact with AJ Addae
She is a chemist and researcher
She is currently in the process of her research of is working to create an inclusive wellness brand
She and her co-founder are researching biomimicry and creating products that benefit all people.
Potentially getting an internship opportunity with her
1-29-26
This semester, I plan to gain exposure to a makeup lab to develop products. Based on my learnings, I would like to find alternatives for makeup products that, instead of clogging pores, benefit the skin. I would like to overall accomplish developing a successful sample product that has been tested on different skin types. I also need to make sure to manage my time better during the process of this and turning in assignments like my upcoming final poster session or my inquire pitch.
Mid Year Reflection 3-2026
Makeup products are made for your face, so why does it cause or worsen skin problems? My lab is to develop makeup products that are beneficial to the skin instead of being harmful, especially for acne. This has been an ongoing struggle for me and with many people throughout their lives, especially teenagers. As a teen, you are experiencing a phase where you are trying new looks as your body is going through changes, which causes many acne or other skin issues, which can then be worsened by makeup. I want to be able to create all my makeup products for it to be beneficial to all people. After creating my tester, I want to test it on student volunteers of multiple different races and genders to guarantee my product is accurately useful to everyone. The foundation that is beneficial to acne is my current goal to develop, in which I have made samples, but have not come out ideally yet, so I'm collecting more research on what is needed to treat specific bacteria growing. Megan, this year, purchased petri dishes for my lab, which I used to take swab samples from students and staff around the school and collect what bacteria grow that don't consist of normal flora. When swabbing, I collected data seeing the difference between bacteria that consist of normal forms and defying the ones that don't. I formulated questions to ask the people that I was swabbing and divided the samples based on those answers, for example, separating the ones that wear makeup from the people that never wear makeup, while also noting the amount of makeup usage. I also noted their skincare routine and the products they use. By the end of this year, I need to formulate a solid plan going into my senior year. I may join WIE next year to focus more on the entrepreneurship side of things, and during the summer, create my product with outside of school resources. I don't currently have any active publications for my project
Mini Project
Once I complete my face swabbing research, my next step will be to find internships or other opportunities for more experience and exposure to further my production in my makeup product, so during that time, during WISRD class, I would like to start a new project.
Bearded Dragon Terrarium
My idea is to create a terrarium that will help support the bearded dragons development in a busy setting, then monitor and research how being in that social environment will affect its ability to adapt and make human connections
Research Question:
How will being in a social environment affect the bearded dragon's ability to adapt and make human connections?
